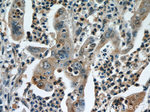
CPB1 Antibody in Immunohistochemistry (Paraffin) (IHC (P))
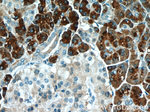
CPB1 Antibody in Immunohistochemistry (Paraffin) (IHC (P))
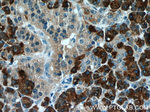
CPB1 Antibody in Immunohistochemistry (Paraffin) (IHC (P))

Search
Proteintech
CPB1 Polyclonal Antibody
{{$productOrderCtrl.translations['antibody.pdp.commerceCard.promotion.promotions']}}
{{$productOrderCtrl.translations['antibody.pdp.commerceCard.promotion.viewpromo']}}
{{$productOrderCtrl.translations['antibody.pdp.commerceCard.promotion.promocode']}}: {{promo.promoCode}} {{promo.promoTitle}} {{promo.promoDescription}}. {{$productOrderCtrl.translations['antibody.pdp.commerceCard.promotion.learnmore']}}
产品信息
12600-1-AP
种属反应
已发表种属
宿主/亚型
分类
类型
抗原
偶联物
形式
浓度
规格
纯化类型
保存液
内含物
保存条件
运输条件
产品详细信息
Immunogen sequence: AEDTVTVEN VLKQNELQYK VLISNLRNVV EAQFDSRVRA TGHSYEKYNK WETIEAWTQQ VATENPALIS RSVIGTTFEG RAIYLLKVGK AGQNKPAIFM DCGFHAREWI SPAFCQWFVR EAVRTYGREI QVTELLDKLD FYVLPVLNID GYIYTWTKSR FWRKTRSTHT GSSCIGTDPN RNFDAGWCEI GASRNPCDET YCGPAAESEK ETKALADFIR NKLSSIKAYL TIHSYSQMMI YPYSYAYKLG ENNAELNALA KATVKELASL HGTKYTYGPG ATTIYPAAGG SDDWAYDQGI RYSFTFELRD TGRYGFLLPE SQIRATCEET FLAIKYVASY VLEHLY (73-417 aa encoded by BC015338)
靶标信息
Three different procarboxypeptidases A and two different procarboxypeptidases B have been isolated. The B1 and B2 forms differ from each other mainly in isoelectric point. Carboxypeptidase B1 is a highly tissue-specific protein and is a useful serum marker for acute pancreatitis and dysfunction of pancreatic transplants. It is not elevated in pancreatic carcinoma.
仅用于科研。不用于诊断过程。未经明确授权不得转售。
生物信息学
蛋白别名: Carboxypeptidase B; carboxypeptidase B1 (tissue); Pancreas-specific protein; pancreatic carboxypeptidase B; pancreatic carboxypeptidase B1; PASP; procarboxypeptidase B; protaminase; tissue carboxypeptidase B
基因别名: 0910001A18Rik; 1810063F02Rik; 2210008M23Rik; AI504870; CPB; CPB1; PASP; PCPB
UniProt ID: (Human) P15086
Entrez Gene ID: (Human) 1360, (Mouse) 76703, (Rat) 24271